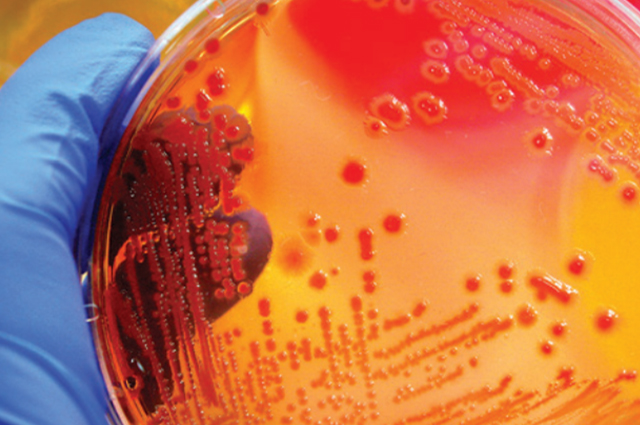

山水化工提供一线品牌PVC助剂
专注PVC行业助剂、聚合世界头部品牌的高品质PVC添加剂、助剂,近30年的行业沉淀与 不断积累,优选的产品与稳健的服务,让您的产品更胜人一筹,丰富的产品线让您可以实 现更高要求的应用。
广州山水新材料 专业助剂 专心服务热线 020-84158411
专注PVC行业助剂、聚合世界头部品牌的高品质PVC添加剂、助剂,近30年的行业沉淀与 不断积累,优选的产品与稳健的服务,让您的产品更胜人一筹,丰富的产品线让您可以实 现更高要求的应用。

Vulcabond?液体粘合剂用于PVC塑料溶胶,可涂覆到聚酯纤维和尼龙纤维上,制成PVC涂层织物,用于建筑和运输行业。
Valtris是工业应用杀菌剂领域的领导者,其Intercide?品牌下拥有经过长时间研发的全面抗菌产品系列。
良好的沟通,让您我能始终紧跟时代的前沿技术,保持产品的竞争力
2026年4月21日~26日,广州山水新材料有限公司在上海国家会展中心Chinaplas国际橡塑展上,展出英国 […]
2025年4月15日18日,广州山水新材料(广州山水化工)参展了2025年深圳ChinaPlas国际橡塑展,广 […]
公司名称变更告知函 尊敬的客户及合作伙伴:因公司发展需求,自2025年3月26日起,我司名称由“广州山水化工有 […]
粘合剂 Vulcabond™ MDX 已整柜到货
Valtris中国区服务经理到山水化工进行产品应用推广培训